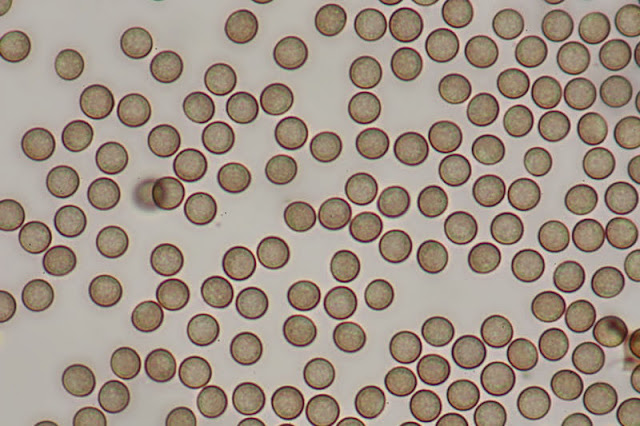

Diminuta especie en forma de pelos
apretados marrones oscuros que manchan de polvo marrón al tocarlos y se
desmenuzan en esporangios cilíndricos y alargados a modo de gruesos pelos al
tocarlos. VER DESCRIPCIÓN COMPLETA
Presenta un capillicio a modo de andamiaje para sostener las esporas, formado por una columela central filiforme muy sutilmente adelgazada hacia la extremidad que es una continuidad del pie.
De la columela central que surge una red de finísimos filamentos entrelazados entre los que se sostienen millones de esporas.
Estos filamentos del capillicio se engruesan en algunos ángulos para dar cierta consistencia a la estructura.
Esporas esféricas, lisas o muy sutilmente punteadas, pero no reticuladas, si las observamos a gran aumento, ocráceas o color canela al microscopio, en nuestras muestras de 7.1 [7.4 ; 7.5] 7.8 × 6.6 [7 ; 7.1] 7.5 micras.